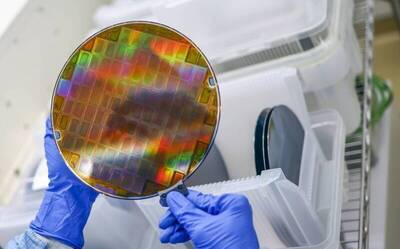
晶片新聖地不在台灣？這公司送1設備上太空 晶片純度比地球高4千倍

風神颱風與東北季風共伴效應 澎湖出現10級強陣風
2025/10/20 14:58 記者劉禹慶/澎湖報導
風神颱風與東北季風「共伴效應」,讓路樹攔腰折斷。(記者劉禹慶攝)
風神颱風外圍環流影響,加上東北季風「共伴效應」,澎湖群島出現10級強陣風,藍色公路全數中斷,直接影響海運交通,更讓澎湖物資無法進入,若再持續2至3天就有斷炊危機。湖西鄉鼎灣路段路樹不堪強風攔腰折斷,警方出動維持交通秩序。
澎湖縣公共車船管理處公告,今日南海之星2號交通船,因受輕度颱風風神外圍環流及東北季風「共伴效應」影響,海象不佳,考量旅客及航行安全,宣布南海交通船停航,其餘各地交通船也宣布停航,貨輪也不敢航行。
另外,澎湖氣象站也發布強風通報(瞬間風),湖西氣象站(湖西鄉) 瞬間風速觀測達8級風以上標準,請注意防範並隨時注意氣象署最新氣象資訊,東吉島最大陣風達到10級,望安鄉也出現8級強風,較大風速氣象站與達標觀測值排序(單位:公尺/秒),湖西氣象站(湖西鄉):22.6、西嶼氣象站(西嶼鄉):21.4。
另外,澎湖203號縣道湖西鄉鼎灣段,1棵南洋杉行道樹因不堪強風蹂躪,直接攔腰折斷在路中央,警方據報後,先將行道樹移到路邊,交由湖西鄉公所清潔隊處理善後。
由於中秋過後,就是澎湖東北季風起,今年時序相當準,中秋甫過就起風,而且風力不容小覷,對於澎湖人而言司空見慣,卻震撼抵澎開會或參加廟會、運動賽事的民眾。

南海之星2號因風浪不佳,20日宣布停航。(記者劉禹慶攝)